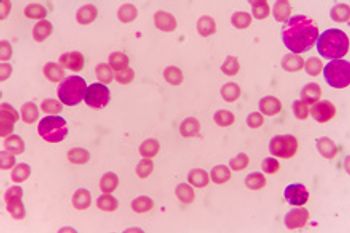

Camcevi is the first ready-to-inject sterile formulation of leuprolide mesylate for subcutaneous injection that comes in a pre-filled syringe with no mixing required.

Camcevi is the first ready-to-inject sterile formulation of leuprolide mesylate for subcutaneous injection that comes in a pre-filled syringe with no mixing required.

Pluvicto is the first targeted radioligand therapy for treatment of progressive, PSMA-positive metastatic castration-resistant prostate cancer.

The FDA has asked for an additional clinical trial with overall survival as the endpoint.

The FDA also approved a companion diagnostic to select patients with mismatch repair deficiency who would be eligible for treatment with Keytruda.

Opdualag is a first-in-class immunotherapy that combines Opdivio with the novel LAG-3-blocking antibody relatlimab.

The American Cancer Society’s 2022 statistical report shows that the 30-year trend is continuing.

In an interim analysis, Keytruda/Lynparza did not improve overall survival in patients with metastatic castration-resistant prostate cancer who progressed after treatment with chemotherapy.

After a phase 3 trial showed that Cabometyx/atezolizumab did not improve overall survival in patients with hepatocellular carcinoma, Exelixis officials have said they won’t be submitting an NDA for untreated patients with advanced liver cancer.

Lynparza reduced the risk of death by 32% versus placebo. It is the first targeted treatment for patients with early breast cancer to be used after surgery or prior treatment.

Besremi is included as an option to treat the rare blood disorder polycythemia vera regardless of treatment history and for use in both low- and high-risk settings.

Aadi Bioscience recently launched Fyarro, the first FDA-approved therapy to treat an ultra-rare sarcoma.

This is the first generic available for Revlimid in the United States.

Amneal Pharmaceuticals received approval for Releuko to decrease incidence of infection after chemotherapy.

Despite the promise of savings billions of dollars in the United States, adoption of biosimilars has been slow. A roundtable discussion among employers highlighted some of the barriers, including formulary design and drug pricing and rebates.

Dr Al-Hendy discusses the impact UF has on a patient’s life and their typical patient journey through the healthcare system.

Ayman Al-Hendy, MD, PhD, FRCSC, FACOG, CCRP, provides a comprehensive background on uterine fibroids, explaining everything from clinical burden to symptoms.

Biden is reviving the program he headed as vice president with the goal of reducing the cancer mortality rate and improving the experience of patients and their loved ones.

Price increases on promising non–small cell lung cancer drugs despite evidence price competition raise concerns about affordability.

The introduction of an electronic tracking system decreased the time from hepatocellular carcinoma (HCC) diagnosis to treatment by more than a month.

The global cancer immunotherapy market is set to grow at a compound annual growth rate, or CAGR, of 12.6% to $277.1 billion by 2030.

But the future of value-based care in oncology is uncertain with no certain successor to the Oncology Care Model in sight.

Reporting of PRO in oncology clinical trials increased after standards from ISOQOL and others were published in 2013.

Patients with a variety of cancers spent much more money out of their own pocket than those in traditional plans. Some may be delaying treatment due to higher costs.

Because of a COVID-19 related shortage, facilities may not have immediate access to Actemra, which is required as part of the REMS programs for CAR T-cell therapies.
Blood cancer patients who had at least some antibodies after the first two doses are likely to produce large amounts after the third vaccination.